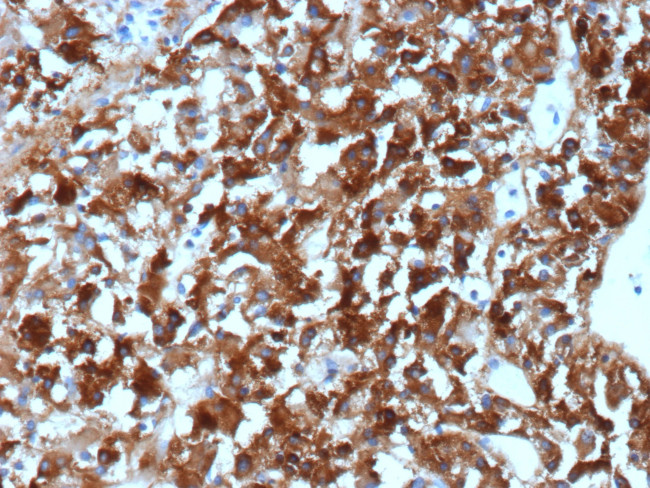
Clusterin/Apolipoprotein J (APO-J) Antibody in Immunohistochemistry (Paraffin) (IHC (P))

Search
NeoBiotechnologies
Clusterin/Apolipoprotein J (APO-J) Monoclonal Antibody (CLU/4740)
{{$productOrderCtrl.translations['antibody.pdp.commerceCard.promotion.promotions']}}
{{$productOrderCtrl.translations['antibody.pdp.commerceCard.promotion.viewpromo']}}
{{$productOrderCtrl.translations['antibody.pdp.commerceCard.promotion.promocode']}}: {{promo.promoCode}} {{promo.promoTitle}} {{promo.promoDescription}}. {{$productOrderCtrl.translations['antibody.pdp.commerceCard.promotion.learnmore']}}
图: 1 / 5
Clusterin/Apolipoprotein J (APO-J) Antibody (1191-MSM20-P1ABX) in IHC (P)





产品信息
1191-MSM20-P1ABX
种属反应
宿主/亚型
分类
类型
克隆号
抗原
偶联物
形式
浓度
规格
纯化类型
保存液
内含物
保存条件
运输条件
靶标信息
Isoform 1 functions as extracellular chaperone that prevents aggregation of nonnative proteins. Prevents stress-induced aggregation of blood plasma proteins. Inhibits formation of amyloid fibrils by APP, APOC2, B2M, CALCA, CSN3, SNCA and aggregation-prone LYZ variants (in vitro). Does not require ATP. Maintains partially unfolded proteins in a state appropriate for subsequent refolding by other chaperones, such as HSPA8/HSC70. Does not refold proteins by itself. Binding to cell surface receptors triggers internalization of the chaperone-client complex and subsequent lysosomal or proteasomal degradation. Secreted isoform 1 protects cells against apoptosis and against cytolysis by complement. Intracellular isoforms interact with ubiquitin and SCF (SKP1-CUL1-F-box protein) E3 ubiquitin-protein ligase complexes and promote the ubiquitination and subsequent proteasomal degradation of target proteins. Promotes proteasomal degradation of COMMD1 and IKBKB. Modulates NF-kappa-B transcriptional activity. Nuclear isoforms promote apoptosis. Mitochondrial isoforms suppress BAX-dependent release of cytochrome c into the cytoplasm and inhibit apoptosis. Plays a role in the regulation of cell proliferation.
仅用于科研。不用于诊断过程。未经明确授权不得转售。
篇参考文献 (0)
生物信息学
蛋白别名: Aging associated protein 4; Aging-associated gene 4 protein; aging-associated protein 4; apo j; Apo J a; Apo J alpha; Apo J b; Apo J beta; Apo J α; Apo J β; Apo Ja; Apo Jb; Apo-J; ApoJ a; ApoJ alpha; ApoJ b; ApoJ beta; ApoJ α; ApoJ β; ApoJa; ApoJb; Apolipoprotein J; apolipoprotein J precursor; CLI; Clusterin; Clusterin alpha / beta chain; Complement associated protein SP40; Complement cytolysis inhibitor; complement cytolysis inhibitor precursor; complement lysis inhibitor; Complement-associated protein SP-40,40; epididymis secretory sperm binding protein; GP80; HGNC:2095; Ku70-binding protein 1; Ku70-binding protein 1 (KUB1); MGC24903; NA1/NA2; SGP-2; Sulfated glycoprotein 2; Sulfated glycoprotein 2 (SGP2); Testosterone repressed prostate message 2 (TPRM2B); Testosterone-repressed prostate message 2; TRPM-2; unnamed protein product
基因别名: AAG4; APO-J; APOJ; CLI; CLU; CLU1; CLU2; KUB1; NA1/NA2; SGP-2; SGP2; SP-40; TRPM-2; TRPM2
UniProt ID: (Human) P10909
Entrez Gene ID: (Human) 1191